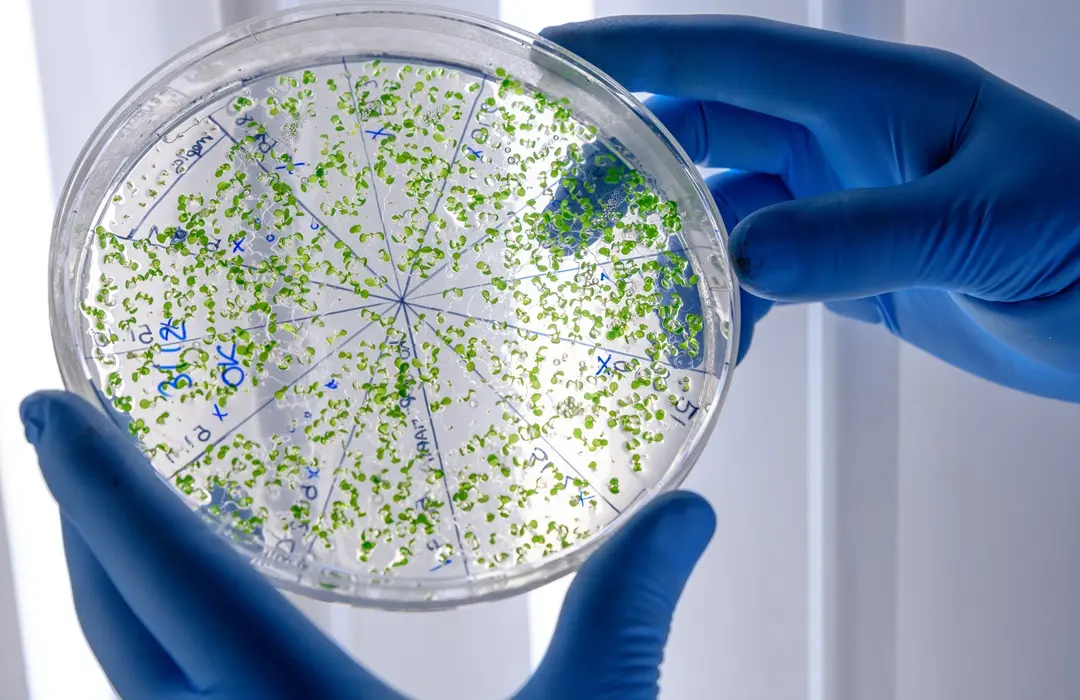

Anatur! Blog
Ételmérgezés: tünetei, megelőzés és teendők


Mi az ételmérgezés és hogyan kerülhető el?
Az ételmérgezés nagyon sokakat érint, és gyakran épp akkor jelentkezik, amikor a legkevésbé számítunk rá: egy gyors ebéd, egy vendéglői étel vagy akár egy otthon tárolt maradék is okozhat problémát. A jó hír, hogy a legtöbb eset megelőzhető – ha tudjuk, milyen hibák vezetnek ételmérgezéshez, és milyen jelekre kell figyelni.
Ebben az útmutatóban végigvesszük a leggyakoribb kiváltó okokat, a tipikus tüneteket, azokat a lépéseket, amelyekkel biztonságosabbá tehetjük a konyhát és a legfontosabb teendőket ételmérgezés esetén.
Mi számít ételmérgezésnek?
Az ételmérgezés olyan állapot, amikor valamilyen kórokozó vagy toxin kerül az élelmiszerrel a szervezetbe, és rövid időn belül panaszokat okoz. Ez lehet fertőzés (baktérium, vírus, parazita) vagy méreganyaggal kapcsolatos reakció.
Ételmérgezés vagy ételfertőzés?
A hétköznapi nyelv a kettőt egynek látja, de nem teljesen ugyanazok.
A különbség lényege:
- Ételfertőzés: a kórokozó maga okozza a tüneteket.
- Ételmérgezés: a kórokozó által termelt toxin váltja ki a panaszokat.
A gyakorlatban ez főleg a tünetek gyorsaságában mutatkozik meg.

Mi okozza leggyakrabban az ételmérgezést?
A problémát az esetek nagy részében baktériumok okozzák, de nem szabad megfeledkezni a vírusokról, parazitákról és a toxintartalmú élelmiszerekről sem.
Baktériumok – a leggyakoribb kiváltók
A legismertebb kórokozók:
- Salmonella
- Campylobacter
- E. coli
- Listeria
- Staphylococcus aureus
A legtöbbjüknél közös, hogy nedves, langyos környezetben gyorsan szaporodnak, ezért a megfelelő hűtés és hőkezelés kulcsfontosságú.
Vírusok – gyorsan terjednek, gyorsan okoznak tüneteket
A norovírus és a rotavírus akár órák alatt rosszullétet okozhat. Ezek jellemzően közösségekben és fertőzött kézről terjednek.
Paraziták – ritkábbak, de komolyan veendők
A Giardia és más paraziták szennyezett vízzel vagy rosszul kezelt élelmiszerrel kerülhetnek be a szervezetbe.
Toxinok – amikor maga az étel bomlik
Ide tartoznak például:
- a penészgombák toxinjai,
- a romlott halakban megjelenő hisztamin,
- vagy a romlás során keletkező baktériumtoxinok.
Ezeket sokszor a főzés sem semlegesíti, ezért fontos a friss, biztonságos alapanyag.

A gombák okozta ételmérgezés
Ősszel és kora télen még mindig sokan járnak gombát gyűjteni. Még novemberben is találkozhatunk laskával, fülőkével, trombitagombával vagy őzlábfélékkel – de ezzel együtt nő a tévedés kockázata is.
Miért veszélyesebb a gomba, mint más élelmiszerek?
A gomba sejtfalának felépítése és a benne lévő toxinok miatt:
- gyorsan romlik,
- könnyen átveheti a környezet szennyeződéseit,
- számos mérgező faj megtévesztően hasonlít az ehetőkre.
Nem csak a mérgező fajok jelentenek veszélyt. Az ehető gombák is okozhatnak ételmérgezést, ha rosszul tárolják vagy nem elég frissen kerülnek az asztalra.
Mely mérgező fajokkal lehet még késő ősszel is összefutni?
Ebben az időszakban még találkozhatunk:
- gyilkos galóca fiatal példányaival,
- különböző susulyka fajokkal,
- tölcsérgombák között megtévesztő, nem ehető változatokkal,
- késői laskagombát utánzó, de mérgező rokonnal.
A hidegebb időszakban különösen megtévesztő, hogy a fiatal, még ki nem nyílt példányok nagyon hasonlítanak egymásra.

A gombamérgezések típusai
Gyors (6 órán belül jelentkező) tünetek
Hányás, hasmenés, hasi görcs – ezek sokszor a „gasztroenteritis típusú” gombamérgezések.
Késői (6–24 óra után induló) tünetek
- Itt jellemzően komolyabb toxinok okozzák a bajt, például az amatoxin (gyilkos galóca).
- Ez azért veszélyesebb, mert a tünetek későn jelentkeznek, amikor a toxin már felszívódott.
- Idegrendszeri tüneteket okozó mérgezések
- Ezeket például egyes susulykák okozzák: zavartság, verejtékezés, lassú pulzus is társulhat hozzájuk.
Mi a teendő gyanús gomba fogyasztása után?
- Azonnal orvost kell hívni, még akkor is, ha a tünetek enyhék.
- Érdemes megőrizni a maradék gombát, ételt, hányadékot – ez segít a pontos azonosításban.
- Kórházban speciális protokoll alapján kezelik a gombamérgezéseket, minél hamarabb, annál nagyobb az esély a gyógyulásra.
Ételmérgezés jellemző tünetei, és mikor kell orvos?
A tünetek sokfélék lehetnek, de a klasszikus panaszok közé tartozik:
- hányinger, hányás,
- hasmenés,
- láz, hidegrázás,
- hasi görcsök,
- gyengeség, szédülés.
Mikor kell feltétlenül orvos?
- erős, görcsös hasi fájdalom,
- véres hasmenés,
- tartós hányás,
- magas láz,
- kiszáradás jelei,
- gombamérgezés gyanúja.
Hogyan kezelhető az ételmérgezés otthon?
Enyhébb esetek nagy része pár nap alatt magától is rendeződik, de a szervezet támogatása fontos.
- Folyadékpótlás: víz, tea, elektrolitoldat.
- Kerüljük a tejterméket, zsíros ételeket, alkoholt.
- Könnyen emészthető táplálék: keksz, rizs, pirítós, főtt burgonya.
- Széntabletta a tünetek első óráiban enyhíthet.
- Gombamérgezés gyanúja esetén semmit nem szabad otthon kezelni.

Milyen tünetek esetén hívjunk azonnal mentőt?
Bár az ételmérgezések nagy része otthon is kezelhető, vannak olyan jelek, amelyek sürgős orvosi ellátást igényelnek. Ezek azt jelzik, hogy a szervezet komoly terhelés alatt van, vagy olyan típusú mérgezéssel állunk szemben, amely gyors állapotromlást okozhat.
1. Erős, görcsös, szűnni nem akaró hasi fájdalom
Ha a fájdalom hirtelen kezdődik, éles, görcsös vagy fokozódik, az komolyabb mérgezés, esetenként vérzés vagy gyulladás jele is lehet.
2. Véres hasmenés vagy fekete széklet
Ez a bélfal károsodására utalhat, amit egyes baktériumok vagy toxinok okoznak. Ilyenkor nem szabad várni.
3. Tartós, csillapíthatatlan hányás
Ha a beteg sem vizet, sem teát nem tud bent tartani, néhány óra alatt súlyos kiszáradás alakulhat ki. Ez különösen veszélyes gyerekeknél és időseknél.
4. Magas láz (39°C felett), hidegrázás, erős gyengeség
A magas láz fertőzésre vagy toxikus reakcióra utalhat. Ha ehhez hidegrázás, erős gyengeség vagy szédülés társul, az állapot gyors romlását jelezheti.
5. Neurológiai tünetek – zavartság, beszédzavar, remegés, látászavar
Ezek a gombamérgezések, bizonyos baktériumtörzsek toxinjai vagy kiszáradás okozta elektrolitzavar miatt jelentkezhetnek. Ilyenkor percek is számítanak.
6. Heves szívdobogás, mellkasi fájdalom vagy légszomj
Ezek a tünetek ételmérgezésnél is előfordulhatnak, főként toxinok vagy extrém kiszáradás esetén. Azonnali ellátást igényelnek.
7. Gombamérgezés gyanúja bármilyen tünettel
- ha vadon szedett gombát ettetek,
- ha a gombát nem vizsgálta szakellenőr,
- vagy ha több embernél is egyszerre jelentkeznek panaszok.
Gombamérgezésnél a látszólag enyhe tünetek mögött is lehet súlyos toxikus hatás, ezért nincs helye otthoni kivárásnak.
8. Csecsemők, idősek, várandósok esetén bármilyen súlyosbodó tünet
Ők gyorsabban kiszáradnak, és fogékonyabbak a fertőzésekre. Náluk a „biztos, ami biztos” elv a helyes

Mit tehetünk a megelőzésért?
A legtöbb mérgezés otthon kezdődik, rosszul tárolt ételekkel vagy keresztszennyeződéssel. A biztonságos ételkészítés sok kellemetlenségtől megóvhat.
- Biztonságos élelmiszerkezelés
- Alapos kézmosás
- Nyers és készételek elkülönítése
- Megfelelő hűtés 0–5 °C között
- Alapos hőkezelés
Étkezés vendéglőben
- Csak megbízható helyen
- Kerüld a látványosan állott vagy rosszul tárolt ételeket
- Gombaszezonban különösen fontos
- Vadon termő gombát mindig vizsgáltass meg szakellenőrnél
- A friss gombát ne tárold napokig, hamar romlik
- A gombás ételeket hűtsd le az elkészítést követően

Mit tehetünk magunkért ételmérgezés után?
Az ételmérgezés legtöbbször néhány nap alatt rendeződik, de a szervezetet – különösen a bélrendszert – megviseli a fertőzés vagy a toxinok jelenléte. A hányás és a hasmenés nemcsak folyadékot von el, hanem a bélflóra egyensúlyát is felborítja. Érdemes tudatosan támogatni a regenerációt.
A gyomor-bélrendszer ilyenkor érzékenyebb, ezért először kímélő ételeket érdemes választani:
- főtt burgonya,
- rizs,
- keksz vagy pirítós,
- kevés banán vagy reszelt alma.
A zsíros, fűszeres vagy puffasztó ételeket pár napig célszerű kerülni.
A bélflóra támogatása ételmérgezés utána
Az ételmérgezést követően a bélflóra összetétele átmenetileg megváltozik. A puffadás, a bizonytalan hasi érzés vagy a gyengébb emésztés gyakori. A regenerációt több irányból is lehet segíteni.
1. Probiotikumok – célzott segítség a bélrendszernek
A probiotikumok olyan jótékony baktériumok, amelyek segítenek „újra benépesíteni” a beleket. Ételfertőzés vagy antibiotikum-kezelés után kifejezetten hasznosak lehetnek.
2. Prebiotikus rostok – táplálék a hasznos baktériumoknak
A prebiotikumok olyan rostok (pl. inulin, FOS, banán, zab), amelyek a jó baktériumok növekedését segítik. Ha a gyomor már tolerálja, lassan vissza lehet vezetni az étrendbe.
3. Erjesztett élelmiszerek – természetes támogatók
A fermentált ételek (kefir, joghurt, savanyú káposzta, kombucha) élő kultúrákat tartalmaznak, és finoman támogatják a bélflóra helyreállítását. Az első napokban még nem ajánlottak, de később jó szolgálatot tehetnek.
Folyadékpótlás és elektrolitok
A hányás-hasmenés után a kiszáradás kockázata nagy, ezért:
- víz,
- gyógytea (pl. kamilla, édeskömény),
- elektrolit-oldat
segíthet visszaállítani az egyensúlyt.
Ha a beteg fáradtnak érzi magát, gyakori pulzusgyorsulást vagy fejfájást tapasztal, érdemes kifejezetten pótolni a sókat és ásványi anyagokat.

Mit érdemes megjegyezni?
Az ételmérgezés legtöbbször megelőzhető probléma. Ha figyelünk a frissességre, a higiénére és a biztonságos elkészítésre, jóval ritkábban kerülünk kellemetlen helyzetbe.
A gombaszezon ugyan izgalmas időszak, de fontos óvatosnak lenni – a tévesztés esélye nagyobb, mint gondolnánk.
Ha szeretnél olyan útmutatókat, amelyek hasznosak a mindennapi egészségmegőrzésben, érdemes követni ugyanazt a szakmai szemléletet, amit ebben az anyagban is alkalmaztunk: hiteles források, gyakorlatias tanácsok és emberi hangvétel.
ANATUR TIPP: HA GLUTÉNÉRZÉKENY VAGY, KERESD GLUTÉNMENTES TERMÉKEINKET ITT!




.png)












